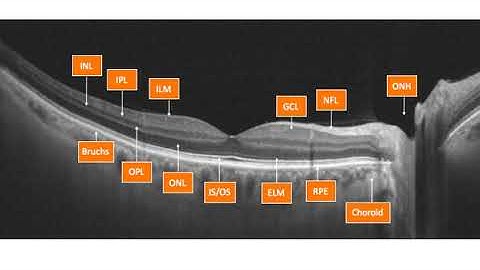
Optovue OCT Interpretation Session 1 OCT Introduction to SD OCT

⬇ DOWNLOAD NOW
Kalau muncul iklan pop-up, tutup lalu klik tombol kembali
Download lagu OCT Interpretation Session 1: OCT Introduction to SD-OCT secara gratis hanya untuk keperluan promosi. Dukung artis favorit kamu dengan membeli musik original di iTunes atau platform resmi lainnya.
Optovue OCT Interpretation Session 1 OCT Introduction to SD OCT
Optovue OCT Interpretation Session 1 OCT Introduction to SD OCT
 Macular OCT Interpretation: A Practical Discussion with Dr. David E. Lederer
Macular OCT Interpretation: A Practical Discussion with Dr. David E. Lederer
 WHAT IS OCT || OCT technology explained ||
WHAT IS OCT || OCT technology explained ||
 OCT: Interpreting the image
OCT: Interpreting the image
 Interpretation of OCT Retina from A-Z
Interpretation of OCT Retina from A-Z
 HOW TO READ MACULAR OCT PRINTOUT? made easy!!
HOW TO READ MACULAR OCT PRINTOUT? made easy!!
 LASIK induced vitreous floaters taken with Optical Coherence Tomography (OCT).
LASIK induced vitreous floaters taken with Optical Coherence Tomography (OCT).
 Optical Coherence Tomography SD OCT Scanner Machine 14 Types Of Image Editing Software
Optical Coherence Tomography SD OCT Scanner Machine 14 Types Of Image Editing Software